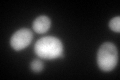
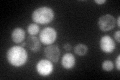

View description
Bifunctional chorismate synthase and flavin reductase, catalyzes the conversion of 5-enolpyruvylshikimate 3-phosphate (EPSP) to form chorismate, which is a precursor to aromatic amino acids
Localization:
Intensity:
Fold change:
Significance:
-
C’ GFP library in SD

cytosol146.19 -
N' NOP1pr-GFP in SD

N/A0 -
N' TEF2pr-mCherry in SD

N/A0 -
N' NATIVEpr-GFP in SD

N/A0 -
N' TEF2pr-VC and Cyto-VN in SD

N/A0 -
C’ GFP library in SD+DTT
cytosol119.630.81No -
C’ GFP library in SD+H2O2

cytosol154.041.05No -
C’ GFP library in Starvation Media
cytosol168.421.15No -
C’ GFP library on the background of Pup2-DaMP

cytosol -
C’ GFP library on the background of CCT mutant

cytosol141.7190.969344No
